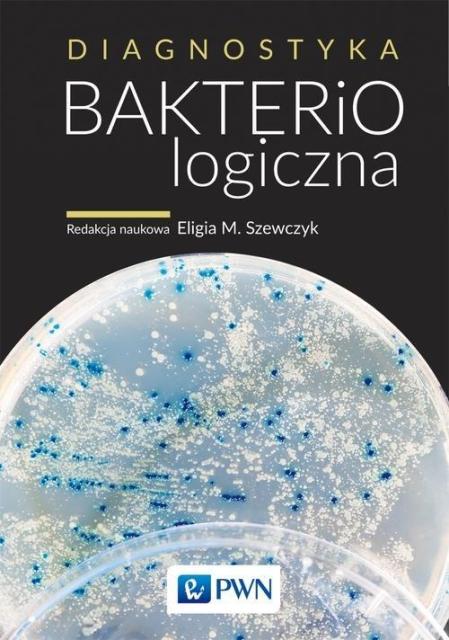

Diagnostyka bakteriologiczna
| Redakcja: | Eligia Szewczyk |
|---|---|
| Wydawcy: | Wydawnictwo Naukowe PWN (2005-2020) Legimi (2019) IBUK Libra (2013) |
| ISBN: | 978-83-01-14473-9, 978-83-01-16060-9 978-83-01-20550-8 |
| Autotagi: | druk książki podręczniki skrypty szkoły wyższe |
| Więcej informacji... | |
|
|
|
|
|
|
Wypożycz w bibliotece
Kup
Recenzje
Opis
| Redakcja: | Eligia Szewczyk |
|---|---|
| Autor: | Eligia Szewczyk |
| Redaktor naczelny: | Eligia Szewczyk |
| Wydawcy: | Wydawnictwo Naukowe PWN (2005-2020) Legimi (2019) IBUK Libra (2013) |
| ISBN: | 978-83-01-14473-9 978-83-01-16060-9 978-83-01-20550-8 |
| Autotagi: | dokumenty elektroniczne druk e-booki epika książki literatura literatura piękna literatura stosowana podręczniki proza publikacje dydaktyczne publikacje fachowe publikacje naukowe skrypty szkoły wyższe zasoby elektroniczne |
Powyżej zostały przedstawione dane zebrane automatycznie z treści
26 rekordów bibliograficznych,
pochodzących
z bibliotek lub od wydawców. Nie należy ich traktować jako opisu jednego konkretnego wydania lub przedmiotu.
z bibliotek lub od wydawców. Nie należy ich traktować jako opisu jednego konkretnego wydania lub przedmiotu.